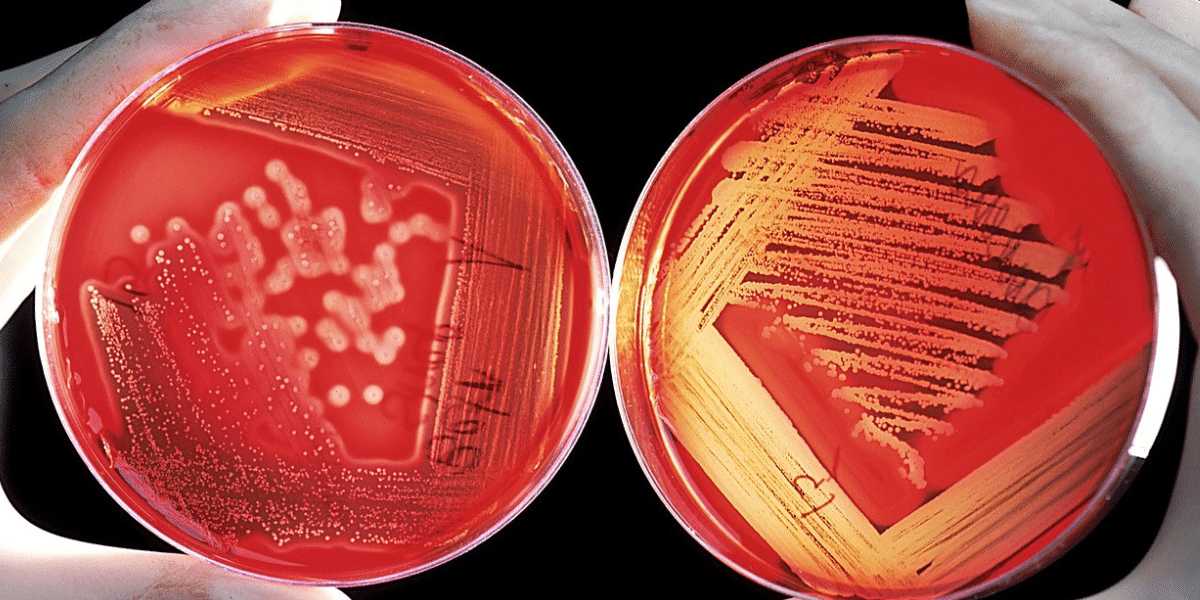

Schimmelige Blumenerde
Ursachen und Lösungen für gesunde Zimmerpflanzen
Willkommen zu unserer Serie Verliebt in Grün: Fragen und Antworten, in der wir uns den häufigsten Garten- und Pflanzenfragen widmen und hilfreiche Tipps geben. Heute geht es um ein Problem, das viele Zimmerpflanzenbesitzer kennen: schimmlige Blumenerde. Wenn deine Zimmerpflanzen in den letzten Wochen einen weißen Belag auf der Erde bekommen haben, erfährst du hier, was du dagegen tun kannst und wie du deine Pflanzen rettest.
Alle meine Zimmerpflanzen haben in den letzten Wochen einen weißen Belag auf der Erde bekommen. Es sieht aus wie Schimmel. Was ist das? Muss ich die Pflanzen jetzt wegwerfen oder was kann ich dagegen tun?
Ursachen für schimmlige Blumenerde
Ich vermute, dass die Erde deiner Zimmerpflanzen nicht richtig kompostiert wurde. Jetzt fault die Erde und es bilden sich Pilze.

Sofortmaßnahmen: Umtopfen in frisches Substrat
Die beste Lösung ist, die Pflanzen umzutopfen, und zwar in ein gutes Markensubstrat. Die Pilze leben von der Erde, und wenn die Erde schlecht ist, werden die Pilze immer wieder auftauchen. Deshalb sollte die Erde ausgetauscht werden. Deinen Pflanzen schadet das nicht.
Schritt-für-Schritt-Anleitung zum Umtopfen
- Vorbereitung: Besorge dir hochwertiges Markensubstrat und saubere Pflanzgefäße.
- Pflanzen entfernen: Nimm die Pflanzen vorsichtig aus den alten Töpfen und entferne so viel von der schimmligen Erde wie möglich.
- Wurzeln prüfen: Überprüfe die Wurzeln auf Anzeichen von Fäulnis und schneide gegebenenfalls beschädigte Teile ab.
- Neue Erde: Fülle die neuen Töpfe mit frischem Substrat und setze die Pflanzen ein.
- Gießen: Gieße die Pflanzen sparsam und achte darauf, dass überschüssiges Wasser gut abfließen kann.
- Präventive Maßnahmen für gesunde Blumenerde: Um zukünftigen Schimmelbefall zu verhindern, achte darauf, nicht zu häufig und nicht zu viel zu gießen. Stelle sicher, dass die Erde zwischen den Wassergaben etwas austrocknen kann. Eine gute Belüftung und das Vermeiden von Staunässe sind ebenfalls wichtig, um die Bildung von Pilzen zu verhindern.